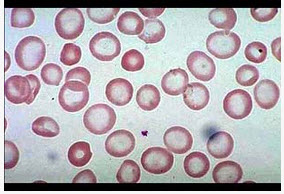

女性28岁,头晕乏力、面色苍白2年余。检验:红细胞2.6×1012/L,血红蛋白60g/L,MCV,MCH,MCHC均低于正常;血涂片如图。最不可能是哪项贫血()
A . 溶血性贫血
B . 再生障碍性贫血
C . 缺铁性贫血
D . 铁粒幼细胞性贫血
E . 慢性感染性贫血
参考答案与解析:
-
相关试题
-
女性28岁,头晕乏力、面色苍白2年余。检验:红细胞2.6×10/L,
-
[单选题]女性28岁,头晕乏力、面色苍白2年余。检验:红细胞2.6×10/L,血红蛋白60g/L,MCV,MCH,MCHC均低于正常;血涂片如图。最不可能是哪项贫血()A .溶血性贫血B .再生障碍性贫血C .缺铁性贫血D .铁粒幼细胞性贫血E .慢性感染性贫血
- 查看答案
-
女性28岁,头晕乏力、面色苍白2年余。检验:红细胞2.8×1012/
-
[单选题]女性28岁,头晕乏力、面色苍白2年余。检验:红细胞2.8×1012/L,血红蛋白60g/L,MCV、MCH、MCHC均低于正常;血涂片见红细胞中央苍白区扩大,可见靶红细胞。除哪项贫血外,其余皆有可能()A . 溶血性贫血B . 缺铁性贫血C . 再生障碍性贫血D . 铁粒幼细胞性贫血E . 慢性感染性贫血
- 查看答案
-
女性28岁,头晕乏力、面色苍白2年余。检验:红细胞2.6×1012/L,血红蛋白
-
[单选题]女性28岁,头晕乏力、面色苍白2年余。检验:红细胞2.6×1012/L,血红蛋白60g/L,MCV,MCH,MCHC均低于正常;血涂片如图。最不可能是哪项贫血()A . 溶血性贫血B . 再生障碍性贫血C . 缺铁性贫血D . 铁粒幼细胞性贫血E . 慢性感染性贫血
- 查看答案
-
女性28岁,头晕、乏力、面色苍白2年余。检验:红细胞2.8×1012/L,血红蛋
-
[单选题]女性28岁,头晕、乏力、面色苍白2年余。检验:红细胞2.8×1012/L,血红蛋白60g/L,MCV,MCH,MCHC均低于正常;血涂片见红细胞中央苍白区扩大,可见靶红细胞。除哪项贫血外,其余皆有可能()A . 溶血性贫血B . 缺铁性贫血C . 再生障碍性贫血D . 铁粒幼细胞性贫血E . 慢性感染性贫血
- 查看答案
-
女性28岁,头晕乏力、面色苍白2年余。检验:红细胞2.6×10£¯L,血红蛋白6
-
[单选题]女性28岁,头晕乏力、面色苍白2年余。检验:红细胞2.6×10/L,血红蛋白60g/L,MCV,MCH,MCHC均低于正常;血涂片如图。最不可能是哪项贫血 ( )A.溶血性贫血B.再生障碍性贫血C.缺铁性贫血D.铁粒幼细胞性贫血E.慢性感染性贫血
- 查看答案
-
女,28岁,头晕乏力、面色苍白2年余。检验结果:红细胞2.8×1012/L.血红
-
[单选题]女,28岁,头晕乏力、面色苍白2年余。检验结果:红细胞2.8×1012/L.血红蛋白6g/L,MCV、MCH、MCHC均低于正常;血涂片见红细胞中央苍白区扩大,可见靶形红细胞。除哪项贫血外,其余皆有可能()A . 溶血性贫血B . 缺铁性贫血C . 再生障碍性贫血D . 铁粒幼细胞贫血E . 慢性感染性贫血
- 查看答案
-
男性,28岁,头昏乏力、面色苍白2年余。检验:红细胞3.0×1012/L,血红蛋
-
[单选题]男性,28岁,头昏乏力、面色苍白2年余。检验:红细胞3.0×1012/L,血红蛋白70g/L,MCV、MCH、MCHC均低于正常;网织红细胞计数0.5%,血涂片见红细胞中央苍白区扩大,可见靶形红细胞。除哪项贫血外,其余均有可能()A . 珠蛋白生成障碍性贫血B . 缺铁性贫血C . 溶血性贫血D . 铁粒幼细胞贫血E . 慢性感染或慢性炎症性贫血
- 查看答案
-
男性,28岁,头昏乏力、面色苍白2年余。检验:红细胞3.0×1012/L,血红蛋
-
[单选题,A2型题,A1/A2型题] 男性,28岁,头昏乏力、面色苍白2年余。检验:红细胞3.0×1012/L,血红蛋白70g/L,MCV、MCH、MCHC均低于正常;网织红细胞计数2%,血涂片见红细胞中央苍白区扩大,可见靶形红细胞。除哪项贫血外,其余均有可能().A . 珠蛋白生成障碍性贫血B . 缺铁性贫血C . 巨幼贫血D . 铁粒幼细胞贫血E . 慢性感染或慢性炎症性贫血
- 查看答案
-
女性,28岁,一年来面色苍白,乏力气短。检验:红细胞2.5×1012
-
[单选题,案例分析题] 女性,28岁,一年来面色苍白,乏力气短。检验:红细胞2.5×1012/L,血红蛋白55g/L,MCV74fl,MCH20pg,MCHC300g/L,网织红细胞1.5%,血涂片红细胞淡染区扩大,初步诊断缺铁性贫血下列实验室检查最有诊断意义的是()A .血清铁测定B . 血清总铁结合力测定C . 血清铁饱和度测定D . 骨髓内外铁染色E . 转铁蛋白饱和度
- 查看答案
-
女,28岁,头晕乏力、面色苍白2年余。检验结果:红细胞2.8×109/L,血红蛋
-
[单选题,A2型题,A1/A2型题] 女,28岁,头晕乏力、面色苍白2年余。检验结果:红细胞2.8×109/L,血红蛋白6%/L,MCV、MCH、MCHC均低于正常;血涂片见红细胞中央苍白区扩大,可见靶形红细胞。除哪项贫血外,其余皆有可能()A . 溶血性贫血B . 缺铁性贫血C . 再生障碍性贫血D . 铁粒幼细胞贫血E . 慢性感染性贫血
- 查看答案
